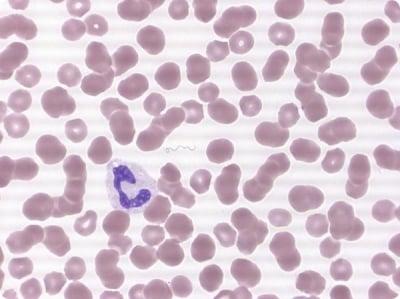
Треска

Поведение на белите мишки
Белите мишки са интересни същества, които показват уникални поведенчески характеристики. Те са стадни...

Белите мишки са интересни същества, които показват уникални поведенчески характеристики. Те са стадни...

Размножаването на белите мишки е подобно на това на други видове мишки и се отличава от размножаването...

Храната на белите мишки не представлява проблем, тъй като те ядат всичко. Те обичат месо във всякакъв...

Белите мишки могат да бъдат отглеждани на специални стелажи, но това изисква доста пространство....

Инфекциите на дихателните пътища са един от най - често срещаните проблеми при кучетата по това...

Вижте топ 5 лечебни билки за кучета....
Какво представлява треската? Какви видове треска има? Какви изменения настъпват по време на треска...

Какво представлява възпалението? Какви са причините за възникването му? Видове възпаление....

Какво представлява отока от патологична гледна точка. Видове отоци....

Тук се включват хиперемията, емболията, тромбозата, кръвоизливите и др....

Външен вид, Космена покривка, Окраски, Отглеждане, Дресировка, История, Здраве и др....

Външен вид, Космена покривка, Окраски, Отглеждане, Дресировка, История, Здраве и др....
